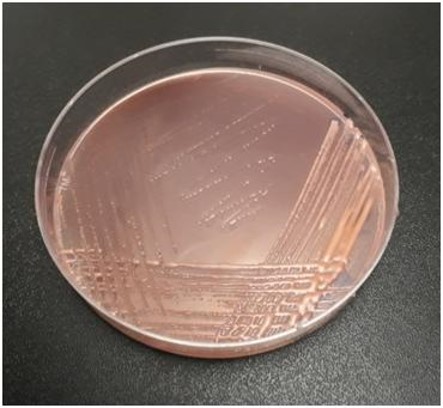

अनुसंधान
वर्तमान में चल रही अनुसंधान परियोजनाएं
| परियोजना सं. | वर्ष | परियोजना शीर्षक | (पी.आई.)/को-पी.आई. |
|---|---|---|---|
| फसल सुधार | |||
| मेगा थीम-1.सोयाबीन जेनेटिक रिसोर्सेस मनेजमेंट – अक्यूजिशन, कंजर्वेशन, केरेक्टरिजेशन, डोक्यूमेंटेशन, एंड यूटीलाइजेशन | |||
| एन.आर.सी.एस. 1.1/87 | 1987-एल.टी. | अग्यूमेंटेशन, मनेजेमेंट एण्ड डोक्यूमेंटेशन ऑफ सोयाबीनजर्मप्लाज्म |
|
| मेगा थीम–जेनेटिक इम्प्रूभमेंट ऑफ सोयाबीन फॉर यील्ड, एग्रोनोमिक ट्रेट्स, रेसिस्टेंस टू बायोटिक स्ट्रेस एण्ड इम्प्रोवमेंट इन क्वालिटी ऑफ सोयाबीन सीड | |||
| एन.आर.सी.एस. 1.6/92 | 1992-एल.टी. | हाइब्रिडिजेशन, सेलेक्शन एण्ड डेवलोप्मेंट ऑफ मल्टिपेरेंट पोपुलेशन फॉर जेनेटिक इम्प्रोवमेंट ऑफ यील्ड पोटेंसियल इन सोयाबीन |
|
| आई.आई.एस.आर 1.33/16 | 2016-एल.टी. | डेवलॉपमेंट ऑफ वाय.एम.वी. रेसिस्टेंट सोयाबीन वेराईटिज यूजिंग मार्कर एसिस्टेड सेलेक्शन |
|
| आई.आई.एस.आर 1.35/17 | 2017-2022 | इम्प्रूभमेंट इन सोयाबीन सीड भायाविलिटी एण्ड स्ट्रेंथ ऑफ सीड कोट बाय जेनेटिक अमेलियोरेशन ऑफ सीड कोट ट्रेट्स |
|
| आई.आई.एस.आर3.11b/18 | 2017-2022 | सोयाबीन इम्प्रूवमेंट अगेंस्ट चारकोल रोट एंड एनन्थ्राकनोज डिजीजेज |
|
| आई.आई.एस.आर 1.34/17 | 2018-2023 | इन्हांसिंग डिजीज रेसिस्टेंस इन सोयाबीन यूसिंग जीनोमिक एप्रोचेज |
|
| आई.आई.एस.आर 3.12/19 | 1992-एल.टी. | सोयाबीन इम्प्रूभामेंट अगेंस्ट डिफ़ोलिएटिंग इंसेक्ट्स |
|
| आई.आई.एस.आर 3.13/19 | 2019-2024 | इवोलूएशन ऑफ़ जर्मप्लाज्म एंड ब्रीडिंग फॉर कोलर रोट डिजीज काउज्ड बाय क्लेरोटीयम रोल्सफ्सी सैक इन सोयाबीन |
|
| मेगा थीम– मेनेजिंग दी इम्पेक्ट ऑफ़ करेंट एंड फ्यूचर क्लाइमेट वेरियेबिलिटी इन सोयाबीन | |||
| डी.एस.आर 5.6a/08 | 2009-2021 | ब्रीडिंग फॉर ड्रोट रेसिस्टेंस / टोलेरेंस वेरैटीज इन सोयाबीन |
|
| डी.एस.आर. 5.6b/18 | 2018-2023 | सोयाबीन ब्रीडिंग फॉर वाटर लोगिंग टोलेरेंस |
|
| आईआईएसआर 3.14/20 | 2020-2025 | जैव रासायनिक और आणविक दृष्टिकोण का उपयोग करके सोयाबीन में अजैविक तनाव सहिष्णुता कारकों की विशेषता |
|
| मेगा थीम–डेवलप्मेंट ऑफ़ स्पेसियालीटी सोयाबीन वेराईटीज फॉर सेकेंडरी एग्रीकल्चर एंड इंडस्ट्रियल यूजेज | |||
| एन.आर.सी.एस. 1.12/02 | 2002-एल.टी. | ब्रीडिंग फॉर फ़ूड ग्रेड कैरेक्टर्स एंड हाई ऑयल |
|
| डी.एस.आर. 1.28/14 | 2014-2021 | मैपिंग क्यू.टी.एल.एस फॉर ओलिक एसिड एंड डेवलपमेंट ऑफ़ हाई ओलिक एसिड |
|
| आई.आई.एस.आर 1.32/16 | 2016-2020 | स्क्रीनिंग सोयाबीन जर्मप्लाज्म फॉर वेजिटेबल टाइप केरेकटेरिस्टीक्स एंड ओप्टिमाइजेशन ऑफ़ प्रोसेसिंग पैरामीटरस |
|
| आई.आई.एस.आर. 3.15/2020 | 2020-2024 | तेल की गुणवत्ता में सुधार के साथ जीनोम संपादित सोयाबीन लाइनों का विकास। |
|
| फसल संरक्षण | |||
| मेगा थीम - सर्विलेंस, फ़ोरकास्टीग एण्ड कंट्रॉल स्ट्रेटसिस फॉर इंसेक्ट पेस्ट कॉम्प्लेक्स इन सोयाबीन | |||
| आई.आई.एस.आर 3.11a/18 | 2018-2020 | मॉर्फोलोजिकल एण्ड मोलेक्यूलर केरेक्टराइजेशन ऑफ मैक्रोफोमिना फेजिओलिना काउजिंग चारकोल रॉट इन सोयाबीन |
|
| आई.आई.एस.आर 3.11c/18 | 2018-2021 | सेलेक्शन ऑफ पोटेंशियल फंगल एण्ड बैक्टेरिया सोयाबीन इंडोफाइट्स एण्ड देयर एवोलूशन अगेंस्ट मेजर डिजिजेज ऑफ सोयाबीन |
|
| फसल उत्पाद | |||
| मेगा थीम–डेवलोप्मेंट ऑफ टेनोलोजिज फॉर सोयाबीन बेस्ड क्रॉपिंग सिस्टम इफिसिएंसी इन्हांसमेन्ट थ्रु रिसोर्स कंजेर्वेशन टेक्नोलोजिज, न्यूट्रीएंट मेनेजमेंट, | |||
| आई.आई.एस.आर. 5.7/17 | 2017-2020 | ड्राउट अमेलियोरेशन इन टर्म्स ऑफ मोर्फो-फिजिओलोजिकल, बायोकेमिकल केरेक्टर्स एण्ड सीड यील्ड इन सोयाबीन थ्रॉव फोलियर एप्लिकेशन ऑफ न्यूट्रिएंटस |
|
| आई.आई.एस.आर. 3.12/2020 | 2020-2023 | राइजोस्फीयर में उन्नत एएमएफ सहजीवन के साथ सोयाबीन की उन्नत मॉडुलन, वृद्धि, उपज के लिए फाइटोहोर्मोन और एएमएफ का पारस्परिक प्रभाव |
|
| आई.आई.एस.आर 6.9/17 | 2017-2020 | बैक्टीरियल मेडिएटेड सल्फर बायो-एबलिटि इन सोयाबीन |
|
| आई.आई.एस.आर9.9/17 | 2017-2020 | डिजाइन,डेवल्प्मेंट एण्ड वेलिडेशन ऑफ(ए) ट्रैक्टर पीटीओ ऑपेरेटेड रूट स्टॉक कटिंग / शेविंग मशीन (बी) ट्रैक्टरपीटीओ ऑपेरेटेड रूट स्टॉक पिकिंग मशीन टू प्रेवेंट बर्निंग ऑफ रूट स्टॉक फॉर वर्टिसोल्स एण्ड एसोसिएटेड स्वॉयल्स |
|
| आई.आई.एस.आर 4.13/17 | 2017-2022 | एवेलूएशन ऑफ टिलेज एण्ड क्रॉप इस्टेब्लिशमेंट एण्ड रेसिड्यू मेनेजमेंट प्रेक्टिसेस फॉर सस्टेनिंग / इमप्रूविंग रेसोर्सेस यूज इफिसिएंसी, स्वॉयल हेल्थ एण्ड क्रॉप प्रोडक्टिविटी इन सोयाबीन बेस्ड क्रॉप्पिंग सिस्टम्स |
|
| आई.आई.एस.आर 4.14/18 | 2018-2023 | एग्रोनोमिक बायोफोर्टिफिकेशन ऑफ माइक्रोन्यूट्रिएंट इन कंजर्वेशन एग्रिकल्चर बेस्ड सोयाबीन-व्हीट क्रॉप्पिंग सिस्टम |
|
| आई.आई.एस.आर 9.10/2019 | 2019-2022 | प्रिडिक्टिंग द इंसिडेंस ऑफ स्टेम प्लाइ, पॉड बॉरर एण्ड बिहार हेयरी केटरपिल्लर इन सोयाबीन– अ जीयो स्पेटियल अप्रोच |
|
| आई.आई.एस.आर 9.11/20 | 2020-2023 | सोयाबीन-गेहूं फसल प्रणाली के तहत पोषक तत्वों की गतिशीलता और खनिज बायोफोर्टिफिकेशन पर राइजोबैक्टीरिया (माइक्रोबियल कंसोर्टिया) को बढ़ावा देने वाले संभावित पौधे के विकास का क्षेत्र मूल्यांकन। |
|
| विस्तार | |||
| मेगा थीम–इंफोर्मेशन डिजिटलाइजेशन, टेकनोलोजी डिस्सेमिनेशन, इम्पेक्ट एनालाय्सिस एण्ड सोसिओ-इकोनोमिक रिसर्च फॉर सोयाबीन | |||
| डी.एस.आर 7.6/19 | 2019-2022 | डेवेलोप्मेंट ऑफ फिल्ड मोनिटेरिंग स्पोर्ट सिस्टम फॉर ऑल इंडिया कॉ-ऑरिडिनेटेड रिसर्च प्रोजेक्ट ट्रायल्स |
|
| आई.आई.एस.आर. 8.17/20 | 2020-2025 | सोयाबीन के टीओटी के लिए आईसीटी उपकरणों और मीडिया का विकास और मूल्यांकन |
|
| आई.आई.एस.आर8.16/18 | 2018-2021 | इम्पेक्ट ऑफ टेकनोलोजिकल इंटेर्वेंशन ऑन सोसियो-इकोनोमिक स्टेटस ऑफ सोयाबीन फार्मर्स अंडर चेंजिंग क्लामेट सिनेरियो – अ कॉम्पेरेटिव एनालायसिस |
|
एक्स्टर्नल फण्डेड (वित्त पोषित) परियोजनाएं
| परियोजना सं. | वर्ष | परियोजना शीर्षक | पी.आई./को-पी.आई. |
|---|---|---|---|
| पी.पी.भी.एफ.आर.ए., भारत सरकार | 2005-एल.टी. | डी.यू.एस. टेस्टिंग ऑफ सोयाबीन – सेंट्रलसेक्टर स्कीम फॉर प्रेटेक्शन ऑफ प्लांटवेराइटिज एण्ड फर्मर्स राइट । |
|
| आई.सी.एस.आर | 2006-LT | आई.सी.ए.आर. सीड प्रोजेक्ट – सीड प्रोडक्शन इन एग्रीकल्चर क्रॉप्स |
|
| डी.बी.टी., भारत सरकार | 2015-2020 | मार्कर असिस्टेंड एलिमेंट ऑफ ओफ-फ्लेवर जेनेरेटिंग लोक्सIIजीन फ्रॉम के.टी.आई. फ्री जेनोटाइप्स |
|
| डी.बी.टी., भारत सरकार | 2017-2020 | असेसिंग द बायो-एबलिटि ऑफ न्यूट्रिएंटस एण्ड रिड्क्शन ऑफ हेवी मेटल्स इन स्वायल अमेंडेड वीथ इनओर्गनिक एण्ड ओर्गनिक वेस्ट इन प्रेजेंस ऑफ ए.एम. फंगी एण्ड बायोचर |
|
| सी.एस.आई.आर, भारत सरकार | 2017-2020 | डेव्लप्मेंट ऑफ एन इफिसिएंट स्केलेबल क्लस्टेरिंग एल्गोरिद्म्स फॉर बिग डेटा एण्ड इंवेस्टिगेशन ऑफ इंटेग्रेटेड सिस्टम फॉर प्रोटिन सिक्यूएंस क्लासिफिकेशन |
|
| डी.ए.सी., कृषि मंत्रालय | 2018-2020 | क्रिऐशन ऑफ सीड हब फॉर एन्हेंसिंग क्वालिटि सीड्स एबिलिटि ऑफ मेजर ऑयल सीड क्रॉप्स अंडर एन.एफ.एस.एम. –ऑयल सीड |
|
| डी.बी.टी., भारत सरकार | 2018-2021 | डेवलॉप्मेंट ऑफ जेनेटिक स्टॉक्स फॉर मेचुरिटी एण्ड ग्रॉथ हेबिट जिंस इन सोयाबीन (ग्लाइसिन मैक्स (एल) मेर.) |
|
| आई.सी.ए.आर. नेटवर्क परियोजना | 2018-2021 | आईडेंटिफेकेशन ऑफ हाई ट्रेह्लॉज – प्रोडुसिंग सोयाबीन राइजोबिया एण्ड देयर इंटेग्रेशन वीथ ए.एम. फंगी फॉए इन्हेंस्ड ड्रॉट टॉलेरेंस इन सोयाबीन |
|
| राष्ट्रीय कृषि विज्ञान फण्ड (एन.ए.एस.एफ.), आई.सी.ए.आर. | 2018-2021 | जेनोमिक्स स्ट्रेटेजिज फॉर इम्प्रूभमेंट ऑफ यील्ड एण्ड सीड कम्पोजिशन ट्रिट्स अंडर ड्रॉट स्ट्रेस कंडिशंस इन सोयाबीन |
|
| आई.आई.टी.ए., पृथ्वी विज्ञान मंत्रालय, भारत सरकार | 2018-2021 | स्ट्रेटेजिज फॉर इन्हेंसिंग यील्ड ऑफ सोयाबीन (ग्लाइसिन मैक्स एल.) एण्ड पिजन-पी (कनानस, कजन, एल) इन इंडिया यूजिंग क्लाइमेट वेरिबिलिटी इंफोर्मेशन एण्ड क्रॉप ग्रॉथ सिमुलेशन मॉडल्स |
|
| डी.बी.टी., भारत सरकार | 2019-2021 | स्टेबलिस्मेंट ऑफ बायोटेक-किसान हब एट मंथन ग्रामीण एवं समाज सेवा समिति |
|
| डी.बी.टी., भारत सरकार | 2019-2021 | एक्सपेंशन ऑफ एक्टिविटिज ऑफ बायोटेक-किसान हब इन सेवेन एस्पिरेशनल डिस्ट्रिक्ट्स इन मध्य प्रदेश अंडर बायोटेक-किसान हब |
|
| विज्ञान एवं अभियांत्रिकी अनुसंधान बोर्ड (एस.ई.आर.बी.) डी.बी.टी., भारत सरकार | 2019-2021 | डेवलप्मेंट ऑफ लेजर बायोस्पेकल टेक्निक फॉर एप्लिकेशंस इन एग्रीकल्चर |
|
| डी.बी.टी., भारत सरकार | 2020-2023 | एक्सीलरेटेड डेवलप्मेंट ऑफ कुनिट्ज ट्रिप्सिन इनहिबिटर फ्री सोयाबीन जीनोटाइप्स वीथ चारकोल रॉट रेसिस्टेंस |
|
| एस.ई.आर.बी., डी.एस.टी., नई दिल्ली | 2021-2024 | जीनोम-वाइड एसोसिएशन मैपिंग ऑफ चारकोल रोट रेजिस्टेंस इन सोयाबीन (ग्लाइसिन मैक्स एल.) |
|
जर्मप्लाज्म संग्रह और मूल्यांकन
एक्सोटिक, इंडिजेंस, प्रजनन लाइनों और जंगली प्रजातियों सहित 4370 सोयाबीन जर्मप्लाज्म एक्सेसनस का संग्रह तथा विभिन्न एग्रोनोमिक लक्षणों के लिए रखरखाव एवं मूल्यांकन किया गया । प्रकाश असंवेदनशील, लॉन्ग जुवेनिल, सूखा और जल भराव सहिष्णुता, जड़ लक्षण आर्चिटेक्चर, YMV प्रतिरोध, रोग प्रतिरोध, रस्ट डिफेरेंसियल्स, स्पोडोप्टेरा के लिए एंटीबायोसिस, कीट सहिष्णुता, सब्जी के प्रकार, शीघ्र परिपक्वता, बोल्ड सीडेड, छोटे बीज, नमक सहिष्णुता, उच्च बीज दीर्घायु, उच्च उपज, उच्च तेल, कम लिनोलेनिक एसिड, नल KTI, लॉक्स 2 मुक्त, उच्च प्रोटीन, उच्च ओलिक, कम लाइपोक्सिलेज और कम यांत्रिक नुकसान जैसे लगभग 210 आनुवांशिक संसाधनों को विभिन्न लक्षणों के लिए पहचाना गया है ।


-
सूखा सहिष्णुता के लिए नई जर्मप्लाज्म लाइनों की पहचान की गई है, जिसे तीन स्तरीय चयन योजना में प्रयोग किया जा रहा है, को सूखा सहन करने वाले जर्मप्लाज्म की पहचान और विलंबित सीनेस को लक्षित करने वाली लाइनें के लिए विकसित किया गया ।
-
लगभग 1167 USDA कोर संग्रह को NBPGR के माध्यम से आयात किए गए थे जो कि पोस्ट एंट्री क्योरेंटाइन के अंतर्गत थे । वनस्पति की पहचान के लिए 112 एवीआरडीसी लाइनों और कनाडा से 62 जर्मप्लाज्म लाइनों को एनबीपीजीआर के माध्यम से आयात किया गया था ।

सोयाबीन की किस्में
जैविक और अजैविक तनावों के लिए अधिक उपज देने वाली किस्में (NRC 2, NRC 7, NRC 12, NRC 37, NRC 86) को विकसित और जारी किया गया ।
-
नौ सोयाबीन किस्मों को जारी करने के लिए पहचान किया गया (NRC 132, NRC 147, NRC 136, NRC 128, NRCSL 1, NRC 130, RSC 11-07, DSb 34 and AMS 2014-1) ।
-
उन्नत बीज संरचना लक्षण के साथ नए जीनोटाइप/किस्मों जैसे उच्च ओलिक एसिड सामग्री, कुनिट्ज़ ट्रिप्सिन इनहिबिटर मुक्त तथा लिपोक्सिलेजेज़ 2 मुक्त किस्मों को विकसित किया गया (NRC 101, NRC 102, NRC 106, NRC 109, NRC 127, NRC 132, NRC 147, and NRC 150) । इसके अलावा, वनस्पति सोयाबीन जीनोटाइप (NRC 105) विकसित हुआ ।
-
चयनित किस्मों / जीनोटाइप्स (NRC 101, NRC 102, NRC 109 and NRC 147) का लिडिंग कॉरपोरेट्स के लिए व्यवसायीकरण किया ।



जैव प्रौद्योगिकी संबंधी दृष्टिकोण
सोयाबीन सुधार कार्यक्रम में आणविक उपकरण और जैव प्रौद्योगिकी संबंधी दृष्टिकोण को लागू किया गया । सोयाबीन में मुंगबिन येलो मोजेक इंडिया वायरस (MYMIV) के लिए जीन इम्पार्टिंग प्रतिरोध की पहचान किया गया और सबसे लोकप्रिय किस्म JS335 में मार्करों असिसटेड प्रजनन का उपयोग करके अंतर्मुखी किया गया है ।
-
क्रोमोसोम 18 पर तुलनात्मक जीनोमिक्स और पूरे जीनोम अनुक्रमण का उपयोग करके सोयाबीन जंग प्रतिरोध के साथ जुड़े नए Rpp1 जीन का पहचान किया गया ।
-
बड़े पैमाने पर आधारित मल्टी-ट्रिट फंक्शनल मार्कर असेस को प्रदर्शन के लिए सोयाबीन जर्मप्लाज्म एक्सेस के जीनोटाइपिंग और प्रजनन संख्या जैसे बढने की क्रिया, फूल का आना, परिपक्वता, ओलिक एसिड, खुशबू, कठिन बीजारोपण, फली बिखरना, फॉस्फोरस उपयोग दक्षता और नमक सहनशीलता जैसे लक्षण के लिए विकसित किया गया ।
-
एक नया एसएनपी मार्कर को पौधे की ऊंचाई से जोड़ा गया है और शीघ्र परिपक्व जीनोटाइप IC15089 में फली की संख्या को दर्ज किया गया । मार्कर असिस्टेड ब्रीडिंग का उपयोग करके जैविक और अजैविक तनावों के बेहतर प्रतिरोध और अद्वितीय बीज रचना लक्षणों के साथ उच्च उपज वाली सोयाबीन किस्मों का विकास किया गया ।
-
लॉग जुबेनिल जीन ई-9 के एक नए कार्यात्मक एलील की पहचान की गई है और इसे मान्यता प्रदान किया गया है ।
बीजोपचार तकनीक
सोयाबीन के लिए बेहतर बीज उपचार तकनीक विकसित किया गया । सैलिसिलिक एसिड, मोलिब्डेनम और बोरिक एसिड के संयोजन से बीज उपचार द्वारा खेत की समस्या, पौधों की वृद्धि, उपज और बीज भंडारण क्षमता में सुधार करता है ।
-
प्य्राक्लॉस्ट्रोबिन और थियोफैनेट मिथाइल, कार्बोक्सिन और थियोमेथोक्सम के साथ सीड पॉलीमर कोटिंग सोयाबीन बीज अंकुरण, पौधे की वृद्धि, रोग और कीट के संक्रमण को कम करने, पौधों की सेहत को बनाए रखने में सुधार करता है जिससे उपज बढ़ती है ।
-
12% की ट्यून (Tune) पर अंकुरण में सुधार के लिए पॉलीमर कोटिंग से बीज के लिए नैनो-जिंक और मैगनीशियम कण का एप्लिकेशन । पॉलीमर कोटिंग के माध्यम से बीज के लिए नैनो- जिंक और मैगनीशियम कण के एप्लिकेशन ने उपज में काफी वृद्धि (17%) की ।
-
टिकाऊ सोयाबीन उत्पादन के लिए उन्नत उत्पादन तकनीक का विकास।


-
सोयाबीन और सोयाबीन आधारित फसल प्रणाली के लिए एकीकृत पोषक तत्व प्रबंधन विधियों का विकास ।
सोयाबीन और सोयाबीन आधारित फसल प्रणाली में खरपतवारों को नियंत्रित करने के लिए नोबल प्रोमिसिंग हर्बिसाइड्स और विकसित एकीकृत खरपतवार प्रबंधन रणनीति की अनुशंसा ।
बदलते जलवायु, उत्पादक और पारिश्रमिक के अनुरूप सोयाबीन आधारित इंटरक्रॉपिंग सिस्टम विकसित किया गया ।
सिमुलेशन मॉडलिंग का उपयोग करके सोयाबीन और अन्य फलदार फसलों की उपज के अंतर का अनुमान लगाया गया ।
-
सोयाबीन की खेती और उत्पादन में सुधार के लिए पंद्रह नए फार्म मशीनरी विकसित किए गए, जिसमें नौ व्यावसायिक हैं ।

-
सोयाबीन के लिए उच्च ट्रेहेलोज एक्कुमुलेटिंग बायोफर्टिलाइज़रके साथ नाइट्रोजन -फिक्सिंग, सूखा सहिष्णु के रूप मेंविकसित नोबल बायोफर्टिलाइज़र [ब्रैडरिज़ोबियम डेक्विजेंस, पीके -472;बी. एलियोनेंसेंस, ईसी 538828] ।एन.सी.बी.आई.जीन सिक्वेंसिंग संख्या JF 792521 और MCC पुणे 2207 के साथ पहचान किए गए Znऔर फॉस्फेट सॉल्युबिलाइजिंग,फाइटेट मिनेरलाइजिंगऔर मल्टी प्लांट ग्रॉथ प्रोमोटिंग बेसिलस आर्य भट्टै(MDSR 14) माइक्रोबियल स्टेन ।
-
किसानों के लिए "उन्नत सोयाबीन उत्पादन प्रौद्योगिकी"विषय पर प्रति वर्ष 75 प्रशिक्षण कार्यक्रम आयोजित किया गया ।
-
संस्थान में वर्ष भर में300 किसानों को प्रशिक्षित किया जाता है, हलांकि 25 गांवों को कृषि उत्पादन प्रौद्योगिकियों में समग्र विकास और प्रशिक्षण के लिए अपनाया गया है।

-
किसानों के लिए मोबाइल ऐप- सोयाबीन ज्ञान (हिंदी और अंग्रेजी संस्करण )विकसित किया गया ।
सोयाबीन रोगों का प्रबंधन
जड़, बीज और फोलियर रोगों (चारकोल रोट, कॉलर रोट, रस्ट, मायरोथेसिय्म लीफ स्पॉट, बैक्टीरियल पुस्ट्यूल, पीला मोज़ेक आदि) के एकीकृत प्रबंधन कार्यक्रम पर काम किया गया है । स्केलेरोटियम रोल्फ़सी और ज़ेंथोमोनस एक्सनोपोडिस पी.वी. ग्लाइसीन में तनाव भिन्नता को स्थापित किया गया है । बड़ी बीमारियों के लिए प्रतिरोधी किस्म / पंक्तियों की पहचान की गई है । ट्राइकोडर्मा विराइड और स्यूडोमोनास फ्लोरेसेंस को कॉलर और चारकोल रोट के प्रबंधन के लिए प्रभावी पाया गया है । कुछ प्राकृतिक पौधों जैसे लॉसनिया, टैगेटेस और एकैसिया को मिरोथेशियम लिफ स्पॉट के प्रबंधन के लिए अनुकुल पाया गया ।
सोयाबीन कीटों का प्रबंधन
किसानों के खेतों में सोयाबीन के लिए एकीकृत कीट प्रबंधन को मानकीकृत और प्रदर्शित किया गया है । स्काउटिंग और मॉनिटरिंग, स्प्रे एप्लिकेशन प्रबंधन और संभावित क्षति के आकलन की सुविधा के लिए, विभिन्न महीनों में होने वाली कीट संबंधित घटनाओं के कैलेंडर को तैयार किया गया है । प्रभावशाली रासायनिक कीटनाशकों की पहचान की गई और उसे अनुशंसित किया गया । डिसिलियोस के प्रबंधन के लिए बेसिलस थुरिंगिनेसिस और व्यूवेरिया बेसियाना पर आधारित माइक्रोबियल कीटनाशक प्रभावशाली पाया गया । बड़े पैमाने पर फील्ड स्क्रीनिंग और प्रयोगशाला स्क्रीनिंग के आधार पर, कीट प्रतिरोध के लिए स्रोतों की पहचान की गई है और कीट-प्रतिरोधी किस्मों को विकसित करने के लिए इसका प्रयोग किया जा रहा है ।
प्लांट पैथोलॉजिकल टेक्नोलॉजी
आर्थिक लाभ की दृष्टि से तैंतीस बीमारियों को उनके वितरण के आधार पर मुख्य तथा गौण के रूप में पहचान कर उसको वर्गीकृत किया गया है । मायरोटेहाइन लीफ स्पॉट, अल्टरनेरिया लीफ स्पॉट, रस्ट, कॉलर रोट, पॉड और स्टेम ब्लाइट, एन्थ्रेक्नोज और पॉड ब्लाइट, बैक्टीरियल पेस्टुले, यलो मोजेक तथा नो पॉडिंग सिंड्रोम को प्रमुखता के रूप में वर्गीकृत किया गया ।
यील्ड लॉस के आकलन में बैक्टीरियल पुस्टुल द्वारा 14% की कमी, मायट्रोहेनेशियम लीफ स्पॉट द्वारा 48%, इंडियन बड ब्लाइट द्वारा 80%, रस्ट से 63%, अल्टरनेरिया लीफ स्पॉट द्वारा 51% और बैंगनी बीज दाग से 36-80% और सी. ट्रंकैटम के कारण स्टेम और पॉड ब्लाइट द्वारा 64% की कमी देखी गई ।
बैंगनी बीज में बीज संक्रमण श्रेणी का एक सकारात्मक सहसंबंध बीज कोट टूटना, मृत बीज की संख्या और अंकुर लंबाई, परीक्षण वजन, एस.एस.एल.आई. अंकुरण और सामान्य अंकुर की संख्या के साथ नकारात्मक देखा गया था ।
प्रयोगों द्वारा सिद्ध हुआ है कि थायरम और कार्बेन्डाजिम के साथ बीज उपचार पर छोटे और सिकुड़े बीजों की तुलना में बोल्ड बीजों के अंकुर मृत्यु दर में कमी आई है और बीज के अंकुर और पैदावार में वृद्धि हुई ।
बीज जनित रोग अर्थात वैक्टेरियल पुस्टुल, मायरोथेसियम लीफ स्पॉट, अल्टरनेरिया लीफ स्पॉट, पर्पल सीड स्पॉट, एन्थ्रेक्नोज और पॉड ब्लाइट तथा अन्य बीमारियाँ जैसे भारतीय बड ब्लाइट और रस्ट जिससे अंकुरण क्षेत्र (20 से 100% तक) प्रभावित होते है, और बीज अंकुरण में प्रतिशत हानि सकारात्मक रूप से अधिकांश बीज जनित संक्रमण के साथ सहसंबद्ध था ।
बैक्टीरियल पुस्टुल, मायरोथेसियम लीफ स्पॉट, इंडियन बड ब्लाइट, अल्टरनेरिया लीफ स्पॉट और रस्ट के कुछ एपिडेमिओलॉजिकल पहलुओं के अध्ययन को लिया गया है ।
दक्षिण भारत के लिए रस्ट इनोकुलम का प्राथमिक स्रोत कोल्हापुर, सांगली, सतारा और बेलगाम जिलों में कृष्णा नदी और उसकी सहायक नदियों के किनारे पर स्थित है । सिंचाई वाले क्षेत्रों में स्व-बुवाई और सर्दियों में बुवाई या इंटरक्रॉप सोयाबीन को ऑफ-सीजन में जंग रोगज़नक़ को रखा जा सकता है और बरसात के मौसम सोयाबीन की फसल के लिए प्राथमिक इनोक्युलम के स्रोत के रूप में कार्य कर सकता है । रस्ट के प्रारम्भ में कॉलेटेरल होस्ट्स की भूमिका बहुत कम या कुछ नहीं हो सकती है । महाराष्ट्र और कर्नाटक में चार हॉट स्पॉट क्षेत्रों की पहचान की गई है जहाँ जंग पहले दिखाई देती है और यहाँ से जंग दूसरे क्षेत्रों में फैली । अध्ययन ने स्पष्ट है कि यह वर्षा के कारण नहीं है बल्कि उच्च सापेक्ष आर्द्रता और अनुकूल तापमान है, जो जंग की शुरुआत और प्रसार के लिए मुख्य कारक हैं । यूरिनियोस्पोर्स के डिफेरेंसियल होस्ट्स और मोर्फोलोजिकल पैरामीटर्स से जुड़े अध्ययन में रस्ट की विभिन्न जातियों की उपस्थिति का संकेत दिया गया ।
कोलेटोट्रिचम, सेप्टोरिया, फुसैरियम और अल्टरनेरिया की प्रजातियां कोटिलेडोनरी स्पॉट से जुड़ी पाई गईं ।
स्केलेरोटियम रोफ़लेसी के दो आइसोलेट्स को कल्चरल कैरेक्टेरिस्टिक्स, स्क्लेरोसियल फोर्मेशन और मोर्फोलोजिकल और पैथोजेनिसिटी के आधार पर 6 समूहों में वर्गीकृत किया गया ।
भारत के विभिन्न कृषि-संबंधी क्षेत्रों से ज़ैंथोमोनस कैंपिस्ट्रिस पी.वी. ग्लाइसीन के पैंसठ आइसोलेट्स को अलग (आइसोलेट्) किए गए थे और उनमें से बीस को शारीरिक और जैव रासायनिक आधार पर कैरेक्टेराइज्ड किए गए थे ।
पैथोजेनिसिटी के आधार पर कोलेटोट्रिकम ट्रंकैटम के 15 आइसोलेट्स को अलग-अलग एग्रोक्लिमैटिक ज़ोन से अलग किए गए, जिसे छः पैथोटाइप्स समूह में बांटा गया ।
सी ट्रंकैटम के अलग-अलग आइसोलेट्स से डीएनए को अलग किया गया है ।
सल्फर, जिंक, कॉपर, आयरन, मैगनीज और कैल्शियम युक्त माध्यम कंटेनर में स्क्लेरोटियम रोल्फसी की वृद्धि बहुत अच्छी थी । स्क्लेरोटिया के वृद्धि और निर्माण के लिए 6.5 और 350C तापमान का पीएच सबसे अनुकूल था । कॉटन ऑयल केक, फार्मयार्ड खाद, बायोगैस घोल और सोया डी ऑइल केक के साथ मिट्टी सुधार को स्केलेरोटियम रॉल्फ्सि के कारण होने वाली पूर्व और बाद की होने वाली मृत्यु दर को कम करने का दावा कर रहे थे ।
कई रोग प्रतिरोधी पंक्तियों/ किस्मों जैसे PK 262, PK 327, PK 471, PK 695, PK 1169, PK 1243, PK 1251, SL 432, SL 459, SL 517, SL 528, TS 99-128, JS 71-05, JS 72-280, JS 75-46, JS 76-206, Bragg, Punjab 1, MACS 58, MAUS 52-1, VLS 2, Monetta, JS (SH) 91-33, JS(SH) 93-01, Himso 1569, NRC 35, NRC 41, NRC 44, RAUS-3, RSC 1, RSC 3, AMS 243, AMS 358, AMS 56, JS 20-29, SL-958, MACS 1336, DS 2614, DS 12-13, PS 1042, SL 688, JS 20-69, JS 20-89, SL 955, SL 983, MACS 1410, MACS 1407 and RVS 2002-4 की पहचान की गई है ।
जंग प्रतिरोधी / सहनशील किस्में / पंक्तियों जैसे PK 1024, PK 1029, JS 80-21, C3P27, JS 90-225, PK 1197, RSC 2, EC 389170, EC 389178, EC 241778, EC 241780 and and DSb 21, DSb 23-2, Phule Kalyani and KDS 726 की पहचान की गई है ।
जर्मप्लाज्म पंक्ति सहित बैक्टीरियल पुस्टुल के प्रतिरोधी किस्मों / लाइनों जैसे EC 389150, EC 389164, EC 390981, EC 390989, EC 390975, EC 390976, EC 390977, EC 391152, EC 391172, EC 391181, EC 393222, EC 393223, EC 393225 and EC 393237 की पहचान की गई । इसी प्रकार, मायरोथेसियम लीफ स्पॉट, कॉलर रॉट, सोयाबीन मोज़ेक, इण्डियन बड ब्लाइट के प्रतिरोधी किस्मों / लाइनों की पहचान की गई हैं ।
कई वर्षो और कई स्थानों AMS 243, AMS 358, AMS 56, JS 20-29, SL-958, MACS 1336 के स्क्रीनिंग के आधार पर RAB और YMV के लिए चारकोल रॉट और DS 2614, DS 12-13, PS 1042, SL 688 को प्रतिरोध के संभावित स्रोतों के रूप में पहचाना गया ।
मक्का और ज्वार तथा बाजरा के साथ 4:2 अनुपात में इंटरकैपिंग, 10 जुलाई तक बुवाई, 30 से 45 सेमी की दूरी एवं 4 लाख पौध/ हेक्टेयर में कम अंकुर मृत्यु दर और उच्च पैदावार पाया गया । हालांकि, मटर के साथ कॉलर रॉट की घटनाओं में वृद्धि हुई ।
कार्बोक्सिन + थिरम @ 2 ग्राम या थीरम और कार्बेन्डाजिम 2: 1 @ 3 ग्रा/ किग्रा बीज के साथ बीजोपचार द्वारा बीज और अंकुरित रोगों के नियंत्रण के लिए बहुत प्रभावी पाया गया । बीजोपचार परिणाम खराब किस्म और अनग्रेड बीज को भी प्रोत्साहित कर रहे थे । बुवाई से 50 दिन पहले बीज उपचार बुवाई के समय की तुलना में अधिक प्रभावी पाया गया ।
बायोकंट्रोल एजेंटों जैसे ट्राइकोडर्मा वायराइड और स्यूडोमोनास फ्लोरेसेंस के साथ बीज उपचार से अंकुर होना, पौधे की संख्या में वृद्धि होना और पहले और बाद के मृत्यु दर को कम किया । टी. हर्ज़ियानम के तीन स्ट्रेंस का कंसोर्टियम भी चारकोल रोट और कॉलर रोट के प्रबंधन के लिए काफी प्रभावी था ।
जिंक का बीज उपचार प्लस मृदा एप्लिकेशन और बोरॉन प्लस सिंचाई फली निर्माण के समय चारकोल रोट के प्रबंधन के लिए काफी प्रभावी था ।
फोलियर रोगों के प्रबंधन के लिए कार्बेन्डाजिम या थियोफैनेट मिथाइल के दो स्प्रे और जंग के लिए हेक्साकोनाजोल, प्रोपिकोनाजेल, ट्रायडाइमफॉन और ऑक्सीकारबॉक्सिन (0.1%) को प्रभावी पाया गया ।
आर2 और आर6 अवस्था में कार्बेन्डाजिम और मेनकोजेब के फोलियर स्प्रे से बीज अंकुरण में वृद्धि होते हैं और बीज बोर्न कवक को कम करते हैं ।
जैव-नियंत्रण एजेंटों ट्राइकोडर्मा के मास मल्टिप्लिकेशन के लिए एग्रोवेस्ट का उपयोग करने के लिए एक विधि विकसित की गई थी ।
ट्राइकोडर्मा एसपीपी को विटावैक्स और थिरम जैसे बीज ड्रेसिंग फंगीसाइड के साथ अनुकूल पाया गया ।
एक वेब-आधारित सोयाबीन रोग के लक्षण, पहचान और प्रबंधन प्रणाली को विकसित किया गया है ।
कीटविज्ञानिक प्रौद्योगिकी
कीटनाशक और रोग प्रबंधन के लिए कीटनाशक-कवकनाशक मिश्रण (एज़ोक्सीस्ट्रोबिन+थायोफेनेट मिथाइल+थायोमेथोक्सम) से 10 मिली/किग्रा बीज की दर से बीज उपचार।
सोयाबीन तना मक्खी प्रबंधन के लिए पहचाने गए कैरोमोन जैसे ट्राइडेकेन, टेट्राडेकेन, नेफ़थलीन, मिथाइल सैलिसिलेट, हेक्साडेकेनॉल, सिस 3-हेक्सिल एसीटेट और पी-ज़ाइलीन।
सोयाबीन को मूंग, उड़द, फ्रेंचबीन, लोबिया और सोयाबीन के बीच स्टेम फ्लाई, मेलानाग्रोमाइज़ा सोजे के लिए सबसे पसंदीदा फसल के रूप में पहचाना गया।
चार प्रकार के वैरिएटल मिश्रण उपचारों (जेएस-9560, जेएस-20-34, एमएयूएस-47 और एमएयूएस-1460), (जेएस-9305, जेएस-2029, आरवीएस-2001-4 और डीएसबी-28-3), (एनआरसी-86, जेएस-335, जेएस-2098 और आरकेएस-45) और (एनआरसी-37, जेएस-9752, आरएससी-1046 और आरकेएस-113) का उनके संबंधित वैरिएटल मिश्रण उपचारों के एकमात्र वैरिएटल उपचारों के विरुद्ध मूल्यांकन किया गया और पाया गया कि कीट-पतंग प्रबंधन के साथ-साथ प्राकृतिक शत्रु आबादी दोनों के संदर्भ में ये उपचार एकल वैरिएटल उपचारों से बेहतर हैं।
सोयाबीन के कीटों के प्रबंधन के लिए नियंत्रण के साथ छह माइक्रोबियल कीटनाशक संयोजनों अर्थात, ब्यूवेरिया बेसियाना (2 किग्रा/हेक्टेयर) + मेटारिज़ियम एनीसोप्लाई (2 किग्रा/हेक्टेयर), नोमुरिया रिलेई (2 किग्रा/हेक्टेयर) + बैसिलस थुरिंजिएंसिस (बीटी) (1 किग्रा/हेक्टेयर), नोमुरिया रिलेई (2 किग्रा/हेक्टेयर) + मेटारिज़ियम एनीसोप्लाई (2 किग्रा/हेक्टेयर), ब्यूवेरिया बेसियाना (2 किग्रा/हेक्टेयर) + नोमुरिया रिलेई (2 किग्रा/हेक्टेयर), ब्यूवेरिया बेसियाना (2 किग्रा/हेक्टेयर) + बैसिलस थुरिंजिएंसिस (बीटी) (1 किग्रा/हेक्टेयर) और मेटारिज़ियम एनीसोप्लाई (2 किग्रा/हेक्टेयर) + बैसिलस थुरिंजिएंसिस (बीटी) (1 किग्रा/हेक्टेयर) का धारवाड़, सीहोर, कोटा, पंतनगर प्रभानी और इम्फाल में परीक्षण किया गया। सोयाबीन के कीटों के प्रबंधन के लिए नोमुरिया रिलेई (2 किग्रा/हेक्टेयर) + बैसिलस थुरिंजिएंसिस (बीटी) (1 किग्रा/हेक्टेयर) उपचार सबसे प्रभावी पाया गया (2.05 लार्वा/मी. बनाम नियंत्रित 5.08 लार्वा/मी.)।
सफेद मक्खी के प्रबंधन के लिए थायमेथोक्सम 70% डब्ल्यूएस को सबसे प्रभावी उपचार माना गया।
विभिन्न कीटों के मौसमी प्रकोप को जानने के लिए कीटों के प्रकोप का एक माहवार (जुलाई से अक्टूबर) कैलेंडर तैयार किया गया है।
नीचे दी गई डाउनलोड फाइल में बीज उपचार और पर्ण उपचार के माध्यम से प्रमुख कीटों के प्रबंधन के लिए उपयुक्त और प्रभावी कीटनाशकों की पहचान की गई और उनकी सिफारिश की गई: :
सीड और फोलिअर ट्रीटमेंट: Download
कीट और रोग नियंत्रण विधियों के प्रभाव का अध्ययन किया गया, और यह निष्कर्ष निकाला गया कि 12.50%, 26.89% और 32.33% की अतिरिक्त उपज अकेले बीमारियों, कीटों और कीटों- बीमारियों दोनों को अकेले नियंत्रित करके प्राप्त किया जा सकता है ।
जर्मप्लाज्म और उन्नत प्रजनन पंक्तियों जैसे TGX 855-53D, TGX 1073-55E, DS 396, EC 34500, EC 39739, EC 109545 (अगेंस्ट डिफ्लेटर), और L 129, L 592 (अगेंस्ट गिर्डल बीटल) के बड़े पैमाने पर फील्ड स्क्रीनिंग के माध्यम से कीटाणु प्रतिरोध के लिए पोटेंसियल डोनर्स की पहचान की गई है । बहुत सारे कीट प्रतिरोध दिखाने वाली कुछ पंक्तियों की भी पहचान की गई । इसके बाद, उपज और उपज कंट्रिबुटिंग कैरेकटर्स के लिए प्रोमिसिंग लाइनों का भी मूल्यांकन किया गया था। पहचान की गई लाइनों को संस्थान के विभिन्न विकास कार्यक्रम में शामिल किया गया है । वाइल्ड सोयाबीन (ग्लाइसिन सोजा) स्टेम फ्लाई और गर्डल बीटल के लिए अत्यधिक प्रतिरोधी पाया गया ।
डिफोलिएटर्स और गर्डल बीटल के प्रतिरोध के लिए फील्ड स्क्रीनिंग हेतु उपयुक्त मापदंडों की पहचान की गई है और तकनीकों को मानकीकृत किया गया है ।
पहली बार, रेडिएशन स्टेम फ्लाई मेलानैग्रोमाइजा सोजे के लिए प्रतिरोध प्रेरित किया गया, उच्च उपज के साथ मिला गया और प्रारंभिक परिपक्वता बताया गया ।
स्वाभाविक रूप से होने वाले पोटेंशियल जैव-नियंत्रण एजेंटों की पहचान की गई :
- पैरासाइट्स: ब्रेकीमेरिया एस.पी.पी., एपेंटेलिस एस.पी.पी. और एक अज्ञात डिप्टेरिअस लार्वा परजीवी (पैरासाइट)
- प्रिडेटर्स : Rराइनोकोरिस फ्यूसिपेस, कैंथेकोनिडिया फुर्सेल्लाटा, क्राइसोपा कार्नेया, ड्रैगन फ्लाई और स्पाइडर
- कीट रोगजनकों : बेवेरिया बेसियाना, नौमेरिया (स्पाइसरिया) रिलेयी, बैक्टीरिया और वायरस, जैव नियंत्रण एजेंटों की अधिकतम गतिविधि, विशेष रूप से परजीवियों को अगस्त के दूसरे सप्ताह के दौरान 20-50% परजीवीकरण होते हुए देखा गया । हरे सेमीलूपर और तंबाकू के कैटरपिलर लार्वा में एंटोमो-पैथोजेनिक फंगी (ब्यूवेरिया बैसियाना और नोमुरिया रिलेई) संक्रमण के लिए उच्च आर्द्रता की स्थिति अनुकूल थी । बी. बैसियाना और एन. रिले के कारण 30 से 40 % लार्वा मृत्यु दर को दर्ज किया गया ।
अन्नोना और इपोमिया की पत्तियों के एक्सट्रेक्ट्स में स्पोडोप्टेरा लिटुरा से कॉन्टेक्ट टॉसिसिटी पाया गया था, क्योंकि उन्होंने क्यूटिकल (छल्ली) को क्षतिग्रस्त कर दिया था, लेंटेना, निकोटियाना, पोंगामिया के एक्सट्रेक्स्ट्स और बबूल, अन्नोना और धतूरा के बीजों में स्टोमक टॉक्सीसिटी पाया गया था, उसी तरह उसने मिड गुट एपिथेलिअल लेयर को नुकसान पहुंचाया था और बबूल, धतूरा और यूकैलिप्टस के एक्सट्रेक्ट्स तथा पेरीट्रॉफ़िक मेम्ब्रान दोनों कॉन्टेक्ट और साथ ही साथ स्टोमक टॉक्सीसिटि के रूप में पाए गए थे जैसा उन्होंने दोनों प्रकार के लक्षणों का प्रदर्शन किया था ।
कीडे-मकोड़े और खरपतवार के विभिन्न अवस्थाओं के लिए कीटनाशकों और शाकनाशियों के सबसे उपयुक्त संयोजनों की पहचान की गई थी । क्लोरेंट्रानिलिप्रोएल 18.5 एससी @ 100 मि.ली. हे. + इमाज़ेथपीर 10 एसएल @ 1.0 ली./हे. का टैंक-मिक्स एप्लिकेशन 15-20 डीएएस पर प्रमुख कीड़े-मकोड़े को मारने और दोनों मोनोकोट और डाइकोट वीड फ्लोरा को दबाने में अत्यधिक प्रभावी था ।
स्पोडोप्टेरा लिटुरा और सेमीलोपर्स प्रबंधन द्वारा एंटोमोपैथोजेनिक नेमाटोड्स (हैटरोरहैब्डिटिस इंडिका और स्टाइनेरनेमा कार्पोकैप्से) के माध्यम से सफलतापूर्वक किया गया । ईपीएन के कारण होने वाली मृत्यु दर को बैसिल्ल्स थुरिंगिनेसिस और रासायनिक कीटनाशक- क्विनालफॉस के साथ तुलना किया गया था ।
विभिन्न फसलों की अवस्थाओं में संक्रमण / क्षति के अलग-अलग स्तरों पर प्रमुख कीटों (डिफोलिएटर्स, गर्डल बीटल, पॉस बोरर और स्टेम फ्लाई) के कारण होने वाले नुकसान की गणना की गई ।
एनेथम ग्रेवोलेंस (सुवा) को लार्वा की संख्या को संतुलित करने के लिए ट्रैप फसल के रूप में सफलतापूर्वक प्रयोग किया गया था । 12:1 और 12:2 के पंक्ति-बद्ध संयोजन तथा सोयाबीन डिफोलिएटर्स के आर्थिक प्रबंधन बहुत प्रभावशाली थे ।
रोटरी वीडर : सोयाबीन हेतु ट्रेक्टर चालित गुड़ाई यंत्र
यह एक नया यंत्र ब्लेड हेरो व ट्रेक्टर चलित रोटरी मेकनिजम का पावर ट्रैक ऑफ (पी.टी.ओ.) द्वारा मिश्रित कर बनाया गया है । संचालन के समय यह खरपतवारों को ब्लेड के द्वारा काटता है एवं उसके बाद मृदा को बारीक करता है । तत्पश्चात् खरपतवारों को रोटरी मेकनिजम द्वारा छोटे-छोटे टुकड़ों में काटता है । इस यंत्र में रोटरी मेकनिजम को सुरक्षा प्रदान करने की व्यवस्था की गई है, जो सोयाबीन के पौधों को सुरक्षा प्रदान करती है । इस व्यवस्था के कारण इस यंत्र का उपयोग सोयाबीन की खड़ी फसल में भी किया जा सकता है । इस यंत्र की निचले लिंक में क्रास-मेकनिजम की व्यवस्था की गई है, जिससे यंत्र की पार्श्व गति (Lateral Movement) का नियंत्रण होता है । इस यंत्र की एक बहुत बड़ी विशेषता यह है कि इस ट्रेक्टर में पतले टायर (8.3 ×32) का उपयोग होता है, इस कारण इस यंत्र का उपयोग खड़ी फसल में भी किया जा सकता है । इस यंत्र द्वारा 8 घण्टे के कार्य अवधि में 4 हेक्टेयर फसल प्रक्षेत्र में संचालन हो सकता है । थोड़ी सी परिवर्तन करके इस यंत्र का अन्य फसलों जैसे कपास आदि में उपयोग हो सकता है ।
सोयाबीन हेतु अंतवर्ती फसल सीड ड्रिल
एक अन्तवर्ती फसल सीड ड्रिल तैयार किया गया है, जिसका उपयोग सोयाबीन की अनुशंसित फसलों जैसे अरहर, मक्का या बाजरा (4:2 पक्तियों) का सोयाबीन के साथ बुआई किया जा सकता है , इसके मध्य में सोयबीन की चार पंक्तियों एवं आजू-बाजू एक-एक पंक्ति इसकी अंतवर्ती फसलों का बुआई किया जा सकता है ।
इस यंत्र में सोयाबीन व अन्य अंतवर्ती में शामिल फसलों के बीज दर को नियंत्रण की व्यवस्था की गई है । इस सीड ड्रिल में सोयाबीन व अन्य फसलों की बीज के साथ उर्वरकों का भी उपयोग करने हेतु अलग-अलग बक्से बनाये गए हैं । यंत्र की परिचालन व बीज दर के नियंत्रण के लिए इसमें 3 स्वतंत्र सेफ्ट की व्यवस्था किया गया है । यह सीड ड्रिल सोयाबीन किसानों को सोयाबीन की अंतवर्ती फसल लेने हेतु एक नये युग का सूत्रपात होगा । यह किसी एक फसल की कीट-व्याधियों, पानी की कमी व मौसम की मार से हानि की जोखिम को अन्य फसलों द्वारा कम करता है ।
सोयाबीन की कंजर्वेशन टिल-ड्रिल
केंद्र में सोयाबीन की 45 से.मी. (पंक्ति से पंक्ति की दूरी) पर 5 पंक्तियों की बुआई हेतु इस ड्रिल का निर्माण किया गया है । इस ड्रिल द्वारा खेतों की ग्रीष्मकालीन जुताई के बाद खेतों की किसी प्रकार की जुताई की आवश्यकता नहीं होती है, इस ड्रिल द्वारा खेतों की जुताई व बुआई एक साथ हो जाता है । इस ड्रिल द्वारा जुताई के समय की बचत के साथ-साथ डीजल की भी बचत होती है, क्योंकि जुताई में लगने वाले डीजल के अलावा इसमें दिए गए व्यवस्था के उपयोग से कम ईंधन लगता है, इसमें डक फूट टाइप टिलेज यंत्र (20 से.मी.) का अटेचमेंट है, जो मृदा की उपरी सतह (7-8 से.मी. की गहराई) में कर्षण करता है । इसमें बुआई के बाद बीज को ढ़कने के लिए व्यवस्था किया गया है । इस यंत्र को खरपतवार नियंत्रण में भी उपयोग में लाया जा सकता है । बीज की बुआई के बाद उसे सामान्य उपयोग की तरह चलाया जा सकता है । मृदा की उपरी परत पर इस यन्त्र का उपयोग होने के कारण मृदा पर पलवार (मल्चिंग) होने के कारण मृदा के अंदर नमी का संरक्षण होता है, जो पौधों के काम आता है एवं सिचाई के खर्च की बचत होती है ।
की-लाइन सीड ड्रिल
सोयाबीन मालवा के पठार की वर्टीसोल की एक प्रमुख फसल है, जहाँ वर्षा जल का असमान वितरण होता है, जिससे फसल में जल की विभिन्न मात्राओं की कमी होती है । इससे फसल की पैदावार पर प्रभाव पड़ता है । उपरोक्त स्थितियों से फसल को बचाने हेतु मृदा में जल का संरक्षण प्रभावी होता है । इस प्रकार के कार्य हेतु यह यंत्र बनाया गया है एवं इसके केंद्र के प्रक्षेत्र में परीक्षण किया गया है । इस यंत्र द्वारा एक साथ पाँच सोयाबीन पंक्तियों की बुआई इस तरह किया जाता है कि एक पंक्ति 20 से.मी. की गहराई द्वारा एक पंक्ति खोलता है जो 15 से.मी. दूसरी तरफ वाली खोलती है जो अधिक पानी को बाहर निकालती है । यह यंत्र करीब 12000 रूपये कीमत की है ।
कम्पोस्ट खाद को बिखेरने वाला ट्रेक्टर ट्राली
यह एक हाइड्रोलिक ट्रेक्टर ट्राली के साथ जोड़कर बनाया गया है । यह अटेचमेंट पिछला फ्लैप ओपनिंग स्क्रू पर लगाया गया है, जो खेत में कम्पोस्ट की बिखराव की दर को नियंत्रित करता है । इसे ट्रेक्टर ट्रॉली की चक्के के साथ एक चेन द्वारा जोड़कर चलाया जाता है । दो रोटर, जिसमें दो सपाट ब्लेड लगे होते हैं का उपयोग कम्पोस्ट खाद की ढेले को तोड़ॅने व उनको बिखेरने के लिए किया जाता है । इस यंत्र द्वारा एक दिन की 8 घण्टे की अवधि में 4-5 हेक्टेयर खेत में कम्पोस्ट खाद का विखराव किया जा सकता है । यह यंत्र फसल के दौरान श्रमिकों का खर्च कम करता है ।

वर्टीसोल हेतु एफ.आई.आर.बी.एफ. मशीन
ट्रेक्टर चालित मेड़ व नाली बनाने वाली यंत्र जो वर्टीसोल में सोयाबीन की फसल हेतु उपयोगी है, को विकसित किया गया है । इसमें मेड़ व नाली की एक के बाद एक संरचना को बनाता है । इसमें मेड़ 20 से.मी. ऊँचा एवं 75 से.मी. चौड़ा होता है । यह ट्रेक्टर चालित यंत्र एक साथ पूरा व दो आधा मेड़ का निर्माण करता है, जिसपर एक साथ छः सोयाबीन पंक्तियों की बुआई की जा सकती है । इस यंत्र के सफलता पूर्वक उपयोग हेतु मानसून की शुरूआत से पहले भूमि की गहरी जुताई व उसके बाद भारी पाटा द्वारा मिट्टी को समतलीकरण अति आवश्यक है । इससे मेड़ व नाली का निर्माण अच्छे से होता है । इसमें अधिक फ्रेम क्लियेरेंस होने के कारण रीजर एवं फ्रेम के बीच रूकावट नहीं होती है । यह यंत्र इस प्रकार से विकसित किया गया है कि बेड बनने के साथ ही इस पर सुगमता के साथ बीज की बुआई हो जाती है । वर्षा जल का संरक्षण भूमि विन्यास, उपयुक्त जुताई या पलवार को अपनाकार कर सकते हैं । यह यंत्र तीनों कार्य करता है ।

इस यंत्र का सत्यापन खरीफ 2002 एवं 2003 में सरोल श्रृंखला (मोंटमोरोलिनिटिर, आई.एस.ओ. हाइपर थरमिक, टाइपिक क्रोमस्टर्रस) पर प्रायोगिक फसलों पर किया गया है एवं इसकी तुलना आमतौर पर किए जाने वाले बुआई (समतल खेत में) से की गई तो यह पाया गया कि इस यंत्र द्वारा की गई बुआई से प्राप्त सोयाबीन उत्पाद परम्परागत समतल पर की गई बुआई से प्राप्त उत्पादन से 32% अधिक थी ।
क्रॉस मेकनिजम
क्रॉस मेकनिजम डिवाइस सीड ड्रिल या अन्य यंत्रों की पार्श्व गति को कम करने या समाप्त करने के लिए बहुत उपयोगी है । यह मेकनिजम ट्रेक्टर के निचले लिंक से जोड़ने व निकालने में आसान है । यह यंत्र खेत में सीधी क्रियाओं में उपयोग किए जाने वाले चेन विधि से अच्छी है । इस पटल यंत्र के उपयोग से सीधी पंक्तियों में बुआई एवं ट्रेक्टर द्वारा फसल में अन्य कर्षण क्रियाओं को सुविधाजनक बनाता है । चेक चेन का उपयोग करके खड़ी फसल में खरपतवारों का नियंत्रण ट्रेक्टर द्वारा करने पर फसल हानि 3-4% कम कर सकते है । स्थानीय कारीगर केवल 80/- रूपये में इस यंत्र को बना सकते हैं,किंतु इस यंत्र को अपने ट्रेक्टर के फ़िटिंग के हिसाब से बनवाया जाना चाहिए ।
सीड ड्रिल के बीज की बुआई के समय बीज को उचित ढ़ंग से ढ़कने पर बीज अंकुरण व उगने में अनुकुल वातावरण मिलता है । इस यंत्र का उपयोग सीड को बुआई के बाद उचित प्रकार से ढ़कने में किया जाता है । इसका उपयोग से बीज इस प्रकार ढ़का जाता है कि जमीन में गिरे बीज को आवश्यक नमी व आक्सीजन मिलता रहता है । इसका उपयोग खेत की गर्मी की जुताई के बाद बिना किसी अन्य कर्षण क्रियाओं के भी किया जा सकता है । यह यंत्र 16 से.मी. चौड़ा एवं 25 से.मी. ऊँचा है । इसमें इनवर्टेड वी नोच जिसकी आधार 10 से.मी. है । इसके कारण यह मिट्टी में गिरे बीज पर मिट्टी उचित तरिके से गिराकर उसको ढ़कती है । साधारणतः बीज की बुआई में 7-13 % बीज खुले रह जाते हैं, जो अंकुरित व उगते नहीं है । यह यंत्र संपूर्ण बीज को उचित ढ़ंग से ढ़क कर पौध संख्या बढ़ाती है । यह यंत्र बड़े आकार के बीजों की भी अंकुरण में सहायता करती है । यहाँ तक कि बुआई के बाद वर्षा हो जाये ।
बीज आवरण
सीड ड्रिल के बीज की बुआई के समय बीज को उचित ढ़ंग से ढ़कने पर बीज अंकुरण व उगने में अनुकुल वातावरण मिलता है । इस यंत्र का उपयोग सीड को बुआई के बाद उचित प्रकार से ढ़कने में किया जाता है । इसका उपयोग से बीज इस प्रकार ढ़का जाता है कि जमीन में गिरे बीज को आवश्यक नमी व आक्सीजन मिलता रहता है । इसका उपयोग खेत की गर्मी की जुताई के बाद बिना किसी अन्य कर्षण क्रियाओं के भी किया जा सकता है । यह यंत्र 16 से.मी. चौड़ा एवं 25 से.मी. ऊँचा है । इसमें इनवर्टेड वी नोच जिसकी आधार 10 से.मी. है । इसके कारण यह मिट्टी में गिरे बीज पर मिट्टी उचित तरिके से गिराकर उसको ढ़कती है । साधारणतः बीज की बुआई में 7-13 % बीज खुले रह जाते हैं, जो अंकुरित व उगते नहीं है । यह यंत्र संपूर्ण बीज को उचित ढ़ंग से ढ़क कर पौध संख्या बढ़ाती है । यह यंत्र बड़े आकार के बीजों की भी अंकुरण में सहायता करती है । यहाँ तक कि बुआई के बाद वर्षा हो जाये ।
कंप्यूटर अनुप्रयोगों की अनुसंधान उपलब्धियां
एक मोबाइल ऐप-सोयाबीन ज्ञान को विकसित किया गया है । इसमें सोयाबीन फसल प्रबंधन सम्बंधित सम्पूर्ण जानकारी समाहित है । यह ऐप हिंदी और अंग्रेजी भाषाओं में भाषा में उपलब्ध है, जिसे गुगल प्ले स्टोर Google Link और Google Link से मुफ्त में डाउनलोड किया जा सकता है । यह किसानों, कृषि सलाहकारों, कृषि छात्रों या अनुसंधान विद्वानों और कृषि सरकारी अधिकारियों के लिए बहुत उपयोगी है ।

सोयाबीन कीड़ों की पहचान और प्रबंधन के लिए एक वेब-आधारित सोयाबीन कीट पहचान और प्रबंधन प्रणाली को विकसित किया गया है । यह सोयाबीन कीड़ों के विभिन्न पहलुओं जैसे आर्थिक नुकसान, कीट हमले के लिए पूर्व-विघटनकारी जलवायु की स्थिति, खरीफ के मौसम में सोयाबीन कीटों की मौसमी घटनाएं, सोयाबीन के अनुकूल कीटों और हिंदी में कीट प्रबंधन अनुसंशित प्रणाली इत्यादि के बारे में जानकारी प्रदान करता है । इसे ASP.NET और SQL बैकएंड पर उपयोग करके विकसित किया गया है । यह किसानों के लिए अपने खेतों में सही समय पर सही निर्णय लेने में बहुत उपयोगी है । कीटों के हमले के कारण होने वाले नुकसान को कम करने के लिए किसानों को उचित और समय पर उपाय करने के लिए यह एक प्रभावी आईटी उपकरण के रूप में कार्य करता है ।
एक वेब-आधारित सोयाबीन जर्मप्लाज़म सूचना प्रणाली (WBGIS) को विकसित किया गया है । यह विभिन्न जर्मप्लाज्म एक्सेस पर सटीक जानकारी और तेजी से सुधार के लिए एक आसान, प्रभावशाली तथा यूजर-फ्रेंडली उपकरण है । इस प्रणाली को वेब तकनीकों जैसे ASP.NET, Hyper Text Markup Language(HTML), JAVA इत्यादि का उपयोग करके विकसित किया गया है।
सोयाबीन में रोग निदान के लिए एक वेब-आधारित विशेषज्ञ प्रणाली विकसित की गई है । यह फजी-लॉजिक इंफ्रेंसिंग पर आधारित है। इसे ASP .NET वेब तकनीकों का उपयोग करके विकसित किया गया है । इसे फसल की एक विशेष अव्स्था में खेतों में किसानों द्वारा देखे गए लक्षणों के आधार पर रोग का मूल्यांकन करता है, डिजिज ज्ञान बेस में संग्रहीत उचित रोग नियमों को लागू करता है और फ़ज़ी-लॉजिक आधारित इंफेरेंसिंग विधि का उपयोग करके, निष्कर्ष निकालता है । यह डायग्नोज्ड रोग के आधार पर एक उपयुक्त नियंत्रण उपाय प्रदान करता है।
एक ज्ञान प्राप्ति प्रणाली को रोग विशेषज्ञ प्रणाली की उप-प्रणाली के रूप में विकसित किया गया है । यह किसी भी फसल के बारे में रोग संबंधित ज्ञान प्रदान करने के लिए एक ग्राफिकल यूजर इंटरफेस प्रदान करता है । वर्तमान में, इसमें 25 प्रकार के सोयाबीन रोगों की जानकारी मौजूद है । इसे ASP.NET वेब तकनीक का उपयोग करके विकसित किया गया है । नॉलेज बेस को SQL सर्वर का उपयोग करके लागू किया जाता है ।

एक इंटेलिजेंट डिजीज ट्यूटर सिस्टम को रोग विशेषज्ञ प्रणाली की उप-प्रणाली के रूप में विकसित किया गया है । यह 25 प्रमुख सोयाबीन रोगों पर पूर्ण ज्ञान प्रदान करने के लिए एक ऑडियो-विज़ुअल प्रशिक्षण उपकरण का कार्य करता है ।
अ.भा.सं.सो.अनु.परि. परीक्षणों डाटा के लिए डेटाबेस प्रबंधन प्रणाली को डेटा के संकलन और अ.भा.सं.सो.अनु.परि. वार्षिक कार्यशाला रिपोर्ट की तैयारी में लगने वाले प्रसंस्करण समय और ड्रगरी को कम करने के उद्देश्य से विकसित किया गया है।
अ.भा.सं.सो.अनु.परि. परीक्षणों डाटा के लिए डेटाबेस प्रबंधन प्रणाली को डेटा के संकलन और अ.भा.सं.सो.अनु.परि. वार्षिक कार्यशाला रिपोर्ट की तैयारी में लगने वाले प्रसंस्करण समय और ड्रगरी को कम करने के उद्देश्य से विकसित किया गया है।

वेब आधारित वैराइटल सूचना प्रणाली को बहुत ही यूजर फ्रेण्डली तरीके से भारतीय सोयाबीन किस्मों की मॉर्फोलोजिकल केरेक्टर जानकारी को जल्दी और सटीक रूप से प्राप्त करने के लिए विकसित किया गया है । इसमें DUS परीक्षण की भी सुविधा मौजूद है ।

एक किसान सलाहकार प्रणाली को किसानों हेतु सोयाबीन विशेषज्ञों द्वारा सोयाबीन की सम्पूर्ण जानकारी प्रदान करने के लिए विकसित की गई है । यह किसानों के मोबाइल फोन पर एसएमएस के माध्यम से विशेषज्ञों की सलाह को भेजने की सुविधा प्रदान करता है। किसान अपने फसल संबंधी समस्याओं को सोयाबीन फसल विशेषज्ञों के पास भी सीधे भेज सकते हैं।